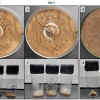

博主实测小米17 Pro Max用iPhone 17 Pro Max贴膜:完美贴合 指纹秒解
今年小米17系列为了全方位对标iPhone 17系列,同样做了三款新机,命名小米17、小米17 Pro、小米17 Pro Max。不光是命名,新机的尺寸也与iPhone 17全系一一对应,同时今年屏幕的R角也更圆润,与iPhone基本完全一致,甚至贴膜都能通用。
博主“我是张大头”晒出了自己给小米17 Pro Max贴的iPhone 17 Pro Max钢化玻璃膜,适配非常完美,包括尺寸、边角都很贴合。
另外,原本上一代的小米15系列超声波屏幕指纹非常挑贴膜,需要尽量薄才能不影响,这一代小米17系列也做出了改进,膜厚度0.7mm也能完美识别指纹,并且是秒解。
根据官方的尺寸数据来看,两大系列六款机型对应的尺寸也非常相似,差别非常细微,具体如下:
小米17:151.1mm*71.8mm*8.06mm
iPhone 17:149.6mm71.5mm*7.95mm
小米17 Pro:151.1mm*71.8mm*8.0mm
iPhone 17 Pro:150.0mm71.5mm*8.75mm
小米17 Pro Max:162.9*mm77.6mm*8.0mm
iPhone 17 Pro Max:163.4mm*78*8.75mm

需要提醒大家的是,虽然看起来贴膜是可以通用,但是两者屏幕的方案不同决定了贴膜也不会真正的完美适配。
因为iPhone 17系列是2.5D边缘,很多贴膜会在边缘做热弯等处理,可能会易碎、容易出现起泡等,还是不建议大家尝试。

热门评论
>>共有0条评论,显示0条